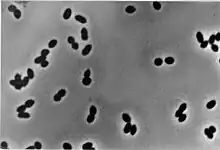

| Nitrosomonas | |
|---|---|
![]() | |
| Nitrosomonas eutropha | |
| Scientific classification | |
| Domain: | |
| Phylum: | |
| Class: | |
| Order: | |
| Family: | |
| Genus: | Nitrosomonas Winogradsky, 1892 |
| Type species | |
| Nitrosomonas europaea | |
| Species | |
|
N. aestuarii | |
Nitrosomonas is a genus of Gram-negative bacteria, belonging to the Betaproteobacteria. It is one of the five genera of ammonia-oxidizing bacteria[2] and, as an obligate chemolithoautotroph,[3] uses ammonia () as an energy source and carbon dioxide () as a carbon source in presence of oxygen. Nitrosomonas are important in the global biogeochemical nitrogen cycle,[4] since they increase the bioavailability of nitrogen to plants and in the denitrification, which is important for the release of nitrous oxide, a powerful greenhouse gas.[5] This microbe is photophobic, and usually generate a biofilm matrix, or form clumps with other microbes, to avoid light.[6] Nitrosomonas can be divided into six lineages: the first one includes the species Nitrosomonas europea, Nitrosomonas eutropha, Nitrosomonas halophila, and Nitrosomonas mobilis. The second lineage presents the species Nitrosomonas communis, N. sp. I and N. sp. II, meanwhile the third lineage includes only Nitrosomonas nitrosa. The fourth lineage includes the species Nitrosomonas ureae and Nitrosomonas oligotropha and the fifth and sixth lineages include the species Nitrosomonas marina, N. sp. III, Nitrosomonas estuarii and Nitrosomonas cryotolerans.[7]
Morphology
All species included in this genus have ellipsoidal or rod-shaped cells in which are present extensive intracytoplasmic membranes displaying as flattened vesicles.[2]
Most species are motile with a flagellum located in the polar region of the bacillus. Three basic morphological types of Nitrosomonas were studied, which are: short rods Nitrosomonas, rods Nitrosomonas and Nitrosomonas with pointed ends. Nitrosomonas species cells have different criteria of size and shape:[7]
N. europaea shows short rods with pointed ends cells, which size is (0.8-1.1 x 1.0- 1.7) µm; motility has not been observed.[7]
N. eutropha presents rod to pear shaped cells with one or both ends pointed, with a size of (1.0-1.3 x 1.6- 2.3) µm. They show motility.[7]
N. halophila cells have a coccoid shape and a size of (1.1-1.5 x 1.5- 2.2) µm. Motility is possible because of a tuft of flagella.[7]
N. communis shows large rods with rounded ends cells which size is (1.0-1.4 x 1.7- 2.2) µm. Motility has not been observed here.[7]
N. nitrosa, N. oligotropha, and N. ureae cells are spheres or rods with rounded ends. Motility has not been observed in them as well.[7]
N. marina present slender rod cells with rounded ends with a size of (0.7-0.9 x 1.7- 2.2) µm.[7]
N. aestuarii and N. cryotolerans present rod shaped cells.[7]
Genome
Genome sequencing of Nitrosomonas species has been important to understand the ecological role of these bacteria.[5]
Among the various species of Nitrosomonas that are known today, the complete genomes of N. ureae strain Nm10, and N. europaea, N.sp. Is79 have been sequenced.[8]
Ammonia-oxidation genes
All these species are characterized by the presence of the genes for the ammonia oxidation. The first enzyme involved in the ammonia oxidation is ammonia monooxygenase (AMO), which is encoded by the amoCAB operon. The AMO enzyme catalyzes the oxidation from (ammonia) to (hydroxylamine). The amoCAB operon contains three different genes: amoA, amoB and amoC. While N. europaea presents two copy of the genes, N. sp. Is79 and N. ureae strain Nm10 have three copy of these genes.[9][10]
The second enzyme involved in the ammonia oxidation is hydroxylamine oxidoreductase (HAO), encoded by the hao operon. This enzyme catalyzes the oxidation from to ,[11] a highly reactive radical intermediate that can be partitioned into both of the main AOB products: , a potent greenhouse gas, and , a form of nitrogen more bioavailable for crops, but that conversely washes away from fields faster.[12] The hao operon contains different genes such as the haoA, that encodes for the functional cytochrome c subunit, the cycA that encodes for cytochrome c554 and the gene cycB that encodes for quinone reductase.[9] These genes are present in different copies in various species; for instance, in Nitrosomonas sp. Is79 there are only three copies, while in N. ureae there are four.[13]
Denitrification genes
Important was the discovery of genes that encodes for enzymes involved in the denitrification. The first gene involved in this process is nirK that encodes for a nitrite reductase with copper. This enzyme catalyzes the reduction form (nitrite) to (nitric oxide). While in N. europaea, N. eutropha and N. cryotolerans nirK is included in a multigenetic cluster,[14] in Nitrosomonas sp. Is79 and N. sp. AL212, it is present as a single gene.[15] A high expression of the nirK gene was found in N.ureae and this has been explained with the hypothesis that the NirK enzyme is also involved in the oxidation of in this species.[16] The second genes involved in the denitrification are norCBQD that decode for a nitric-oxide reductase that catalyze the reduction from (nitric oxide) to (nitrous oxide). These genes are present in N. sp. AL212, N.cryotolerans and N. communis strain Nm2. In the Nitrosomonas europaea these genes are included in a cluster.[17] These genes are absent in N. sp. Is79 and N. ureae.[9] Recently is found the norSY gene that encodes for a nitric-oxide reductase with copper in N. communis strain Nm2 and Nitrosomonas AL212[18][19].
Carbon fixation genes
Nitrosomonas uses the Calvin-Benson cycle as a pathway for the Carbon fixation. for this reason all the species present an operon that encodes for the RuBisCO enzyme.[15] A peculiarity is found in N. sp Is79 in which the two copy of the operon encode for two different forms of the RuBisCO: the IA form and the IC form, where the first one has major affinity with the Carbon dioxide. Other species present different copies of this operon that encodes only for the IA form.[9] In Nitrosomonas europaea was found an operon characterized by five genes (ccbL, ccbS, ccbQ, ccbO and ccbN) that encodes for the RuBisCO enzyme. ccbL gene encodes for the major subunit while ccbS encodes for the minor subunit, these genes are also the most expressed. ccbQ and ccbO genes encoding for a number of proteins involved in the mechanisms of processing, folding, assembling, activation and regulation of the RuBisCO, instead ccbN, encodes for a protein of 101 amino acids, whose function is not known yet. Over these genes has been highlighted the presence of an assumed regulatory gene ccbR (transcribed in opposite direction to other genes) placed at 194 bp upstream of the ccbL gene start coding.[20]
Transporter genes
Since Nitrosomonas are part of the AOB, ammonia carriers are important to them. Bacteria adapted to high concentrations of ammonia can absorb it passively by simple diffusion. Indeed, N. eutropha, that is adapted to high level of ammonia doesn't present genes that encodes for ammonia transporter.[21] Bacteria adapted to low concentrations of ammonia, present transporter (transmembrane protein) for this substrate. In Nitrosomonas two different carriers for ammonia have been identified, differing in structure and function. The first transporter is the Amt protein (amtB type) encoded by amt genes and this was found in Nitrosomonas sp. Is79.[9] The activity of this ammonia carrier depends on the membrane potential.[21] The second was found in Nitrosomonas europaea, where the rh1 gene is present which encodes an Rh-type ammonia carrier. Its activity is independent from the membrane potentia[21] l. Recent research has also linked Rh transmembrane proteins with transport, but it is not clear yet.[22]
Metabolism
Nitrosomonas is one of the genera included in the ammonia-oxidizing bacteria (AOB); AOB use ammonia as energy source and carbon dioxide as the main source of carbon.[23] The oxidation of ammonia is a rate-limiting step in nitrification and plays a fundamental role in the nitrogen cycle, because it transforms ammonia, which is usually extremely volatile, into less volatile forms of nitrogen.[23]
Ammonia-oxidation
Nitrosomonas oxidizes ammonia into nitrite in a metabolic process, known as nitritation (a step of nitrification). This process occurs with the accompanying reduction of an oxygen molecule to water (which requires four electrons), and the release of energy.[24] The oxidation of ammonia to hydroxylamine is catalyzed by ammonia monooxygenase (AMO), which is a membrane-bound, multisubstrate enzyme. In this reaction two electrons are required to reduce an oxygen atom to water:[25]
- NH3 + O2 + 2 H+ + 2 e– → NH2OH + H2O [25]
Since an ammonia molecule only releases two electrons when oxidized, it has been assumed that the other two necessary electrons come from the oxidation of hydroxylamine to nitrite,[26] which occurs in the periplasm and it is catalyzed by hydroxylamine oxidoreductase (HAO), a periplasm associated enzymes.[26]
- NH2OH + H2O → NO2– + 5 H+ + 4 e– [26]
Two of the four electrons released by the reaction, return to the AMO to convert the ammonia in hydroxylamine.[26] 1,65 of the two remaining electrons are available for the assimilation of nutrients and the generation of the proton gradient.[24] They pass through the cytochrom c552 to the cytochrome caa3, then to O2, which is the terminal acceptor; here they are reduced to form water.[7] The remaining 0,35 electrons are used to reduce NAD+ to NADH, to generate the proton gradient.[7]
Nitrite is the major nitrogen oxide produced in the process, but it has been observed that, when oxygen concentrations are low,[7] nitrous oxide and nitric oxide can also form, as by-products from the oxidation of hydroxylamine to nitrite.[24]
The species N. europaea has been identified as being able to degrade a variety of halogenated compounds including trichloroethylene, benzene, and vinyl chloride.[27]
Ecology
Habitat
Nitrosomonas is generally found in highest numbers in all habitat in which there is abundance of ammonia ( environment with plentiful protein decomposition or in wastewater treatment), thrive in a pH range of 6.0–9.0, and a temperature range of 20–30 °C (68–86 °F). Some species can live and proliferate on monuments’ surface or on stone buildings’ walls, contributing to erosion of those surfaces.[6]
It is usually found in all types of waters, globally distributed in both eutrophic and oligotrophic freshwater and saltwater, emerging especially above all in shallow coastal sediments and under the upwelling zones, such as the Peruvian coast and the Arabian Sea,[28][29] but can also be found in fertilized soils.[15]
Some Nitrosomonas species, such as N.europaea, possess the enzyme urease (which catalyzes the conversion of the urea into ammonia and carbon dioxide) and have been shown to assimilate the carbon dioxide released by the reaction to make biomass via the Calvin cycle, and harvest energy by oxidizing ammonia (the other product of urease) to nitrite. This feature may explain enhanced growth of AOB in the presence of urea in acidic environments.[30]
Leaching of soil
In agriculture, nitrification made by Nitrosomonas represents a problem because the oxidized nitrite by ammonia can persist in the soil, leaching, and making it less available for plants.[31]
Nitrification can be slowed down by some inhibitors that are able to slow down the oxidation process of ammonia to nitrites by inhibiting the activity of bacteria of the genus Nitrosomonas and other ammonia-oxidizing bacteria, minimize or prevent the loss of nitrate.[31][32] (Read more about inhibitors in the section 'Inhibitors of nitrification' on this page Nitrification)
Application
Nitrosomonas is used in activated sludge in aerobic wastewater treatment; the reduction of nitrogen compounds in the water is given by nitrification treatment in order to avoid environmental issues, such as ammonia toxicity and groundwater contamination. Nitrogen, if present in high quantities can cause algal development, leading to eutrophication with degradation of oceans and lakes.[33]
Employing as wastewater treatment biological removal of nitrogen is obtained a lower economic expense and less damage caused to the environment compared to physical-chemical treatments.[33]
Nitrosomonas has also a role in biofilter systems, typically in association and collaboration with other microbes, to consume compounds such as or and recycle nutrients. These systems are used for various purposes but mainly for the elimination of odors from waste treatment.[23]
Other uses
Potential cosmetic benefits
N. europaea is a non-pathogenic bacteria which has been studied in connection with probiotic therapies, in which context it may give aesthetic benefits in terms of reducing the appearance of wrinkles.[34] The effectiveness of probiotic products has been studied to explore why N. eutropha, which is a highly mobile bacterium, has become extinct from the normal flora of our skin. It has been studied in connection with the idea of having benefits through the repopulation and reintroduction of N. eutropha to the normal flora of human skin.[35]
See also
References
- ↑ Nakagawa, T; Takahashi, R (2015). "Nitrosomonas stercoris sp. nov., a Chemoautotrophic Ammonia-Oxidizing Bacterium Tolerant of High Ammonium Isolated from Composted Cattle Manure". Microbes and Environments. 30 (3): 221–7. doi:10.1264/jsme2.ME15072. PMC 4567560. PMID 26156554.
- 1 2 Koops, H. P.; Böttcher, B.; Möller, U. C.; Pommerening-Röser, A.; Stehr, G. (1991). "Classification of eight new species of ammonia-oxidizing bacteria: Nitrosomonas communis sp. nov., Nitrosomonas ureae sp. nov., Nitrosomonas aestuarii sp. nov., Nitrosomonas marina sp. nov., Nitrosomonas nitrosa sp. nov., Nitrosomonas eutropha sp. nov., Nitrosomonas oligotropha sp. nov. and Nitrosomonas halophila sp. nov". Microbiology. 137 (7): 1689–1699. doi:10.1099/00221287-137-7-1689. ISSN 1350-0872.
- ↑ Cherif-Zahar, Baya; Durand, Anne; Schmidt, Ingo; Hamdaoui, Nabila; Matic, Ivan; Merrick, Mike; Matassi, Giorgio (2007-12-15). "Evolution and Functional Characterization of the RH50 Gene from the Ammonia-Oxidizing Bacterium Nitrosomonas europaea". Journal of Bacteriology. 189 (24): 9090–9100. doi:10.1128/JB.01089-07. ISSN 0021-9193. PMC 2168606. PMID 17921289.
- ↑ "Nitrosomonas - microbewiki".
- 1 2 Arp, Daniel J.; Chain, Patrick S.G.; Klotz, Martin G. (October 2007). "The Impact of Genome Analyses on Our Understanding of Ammonia-Oxidizing Bacteria". Annual Review of Microbiology. 61 (1): 503–528. doi:10.1146/annurev.micro.61.080706.093449. ISSN 0066-4227. PMID 17506671.
- 1 2 "Nitrosomonas europaea ATCC 19718 - Home". 2009-07-03. Archived from the original on 2009-07-03. Retrieved 2020-11-26.
- 1 2 3 4 5 6 7 8 9 10 11 12 Soliman, Moomen; Eldyasti, Ahmed (June 2018). "Ammonia-Oxidizing Bacteria (AOB): opportunities and applications—a review". Reviews in Environmental Science and Bio/Technology. 17 (2): 285–321. doi:10.1007/s11157-018-9463-4. ISSN 1569-1705. S2CID 90350069.
- ↑ "Genome".
- 1 2 3 4 5 Bollmann, Annette; Sedlacek, Christopher J.; Norton, Jeanette; Laanbroek, Hendrikus J.; Suwa, Yuichi; Stein, Lisa Y.; Klotz, Martin G.; Arp, Daniel; Sayavedra-Soto, Luis; Lu, Megan; Bruce, David (2013-11-01). "Complete genome sequence of Nitrosomonas sp. Is79, an ammonia oxidizing bacterium adapted to low ammonium concentrations". Standards in Genomic Sciences. 7 (3): 469–482. doi:10.4056/sigs.3517166 (inactive 1 August 2023). ISSN 1944-3277. PMC 3764937. PMID 24019993.
{{cite journal}}: CS1 maint: DOI inactive as of August 2023 (link) - ↑ Arp, Daniel J.; Sayavedra-Soto, Luis A.; Hommes, Norman G. (2002-10-01). "Molecular biology and biochemistry of ammonia oxidation by Nitrosomonas europaea". Archives of Microbiology. 178 (4): 250–255. doi:10.1007/s00203-002-0452-0. ISSN 1432-072X. PMID 12209257. S2CID 27432735.
- ↑ Caranto, Jonathan D.; Lancaster, Kyle M. (2017-07-17). "Nitric oxide is an obligate bacterial intermediate produced by hydroxylamine oxidoreductase". PNAS. 114 (31): 8217–8222. Bibcode:2017PNAS..114.8217C. doi:10.1073/pnas.1704504114. ISSN 1091-6490. PMC 5547625. PMID 28716929. S2CID 205284517.
- ↑ Lancaster, Kyle M. D.; Caranto, Jonathan D.; Majer, Sean H.; Smith, Meghan A. (2018-03-21). "Alternative Bioenergy: Updates to and Challenges in Nitrification Metalloenzymology". Joule. 2 (3): 421–441. doi:10.1016/j.joule.2018.01.018.
- ↑ Kozlowski, Jessica A.; Kits, K. Dimitri; Stein, Lisa Y. (2016-04-28). "Complete Genome Sequence of Nitrosomonas ureae Strain Nm10, an Oligotrophic Group 6a Nitrosomonad". Genome Announcements. 4 (2). doi:10.1128/genomeA.00094-16. ISSN 2169-8287. PMC 4786657. PMID 26966201.
- ↑ Rice, Marlen C.; Norton, Jeanette M.; Stein, Lisa Y.; Kozlowski, Jessica; Bollmann, Annette; Klotz, Martin G.; Sayavedra-Soto, Luis; Shapiro, Nicole; Goodwin, Lynne A.; Huntemann, Marcel; Clum, Alicia (2017-03-16). "Complete Genome Sequence of Nitrosomonas cryotolerans ATCC 49181, a Phylogenetically Distinct Ammonia-Oxidizing Bacterium Isolated from Arctic Waters". Genome Announcements. 5 (11). doi:10.1128/genomeA.00011-17. ISSN 2169-8287. PMC 5356046. PMID 28302769.
- 1 2 3 Sedlacek, Christopher J.; McGowan, Brian; Suwa, Yuichi; Sayavedra-Soto, Luis; Laanbroek, Hendrikus J.; Stein, Lisa Y.; Norton, Jeanette M.; Klotz, Martin G.; Bollmann, Annette (2019-11-01). "A Physiological and Genomic Comparison of Nitrosomonas Cluster 6a and 7 Ammonia-Oxidizing Bacteria". Microbial Ecology. 78 (4): 985–994. doi:10.1007/s00248-019-01378-8. hdl:20.500.11755/1f7f7474-07c8-4b67-a2fc-efb83b76ebdd. ISSN 1432-184X. PMID 30976841. S2CID 108292967.
- ↑ Zorz, Jackie K.; Kozlowski, Jessica A.; Stein, Lisa Y.; Strous, Marc; Kleiner, Manuel (2018). "Comparative Proteomics of Three Species of Ammonia-Oxidizing Bacteria". Frontiers in Microbiology. 9: 938. doi:10.3389/fmicb.2018.00938. ISSN 1664-302X. PMC 5960693. PMID 29867847.
- ↑ Chain, Patrick; Lamerdin, Jane; Larimer, Frank; Regala, Warren; Lao, Victoria; Land, Miriam; Hauser, Loren; Hooper, Alan; Klotz, Martin; Norton, Jeanette; Sayavedra-Soto, Luis (2003-05-01). "Complete Genome Sequence of the Ammonia-Oxidizing Bacterium and Obligate Chemolithoautotroph Nitrosomonas europaea". Journal of Bacteriology. 185 (9): 2759–2773. doi:10.1128/JB.185.9.2759-2773.2003. ISSN 0021-9193. PMC 154410. PMID 12700255.
- ↑ Yuichi, Suwa; Norton, Jeanette M.; Bollmann, Annette; Klotz, Martin G.; Stein, Lisa Y.; Laanbroek, Hendrikus J.; Arp, Daniel J.; Goodwin, Lynne A.; Chertkov, Olga; Held, Brittany; Bruce, David (2011-09-15). "Genome Sequence of Nitrosomonas sp. Strain AL212, an Ammonia-Oxidizing Bacterium Sensitive to High Levels of Ammonia". Journal of Bacteriology. 193 (18): 5047–5048. doi:10.1128/JB.05521-11. ISSN 0021-9193. PMC 3165687. PMID 21868805.
- ↑ Kozlowski, Jessica A.; Kits, K. Dimitri; Stein, Lisa Y. (2016-02-25). "Genome Sequence of Nitrosomonas communis Strain Nm2, a Mesophilic Ammonia-Oxidizing Bacterium Isolated from Mediterranean Soil". Genome Announcements. 4 (1). doi:10.1128/genomeA.01541-15. ISSN 2169-8287. PMC 4714114. PMID 26769932.
- ↑ Wei, Xueming; Sayavedra-Soto, Luis A.; Arp, Daniel J. (2004). "The transcription of the cbb operon in Nitrosomonas europaea". Microbiology. 150 (6): 1869–1879. doi:10.1099/mic.0.26785-0. ISSN 1350-0872. PMID 15184573.
- 1 2 3 "Functional and physiological evidence for a Rhesus-type ammonia transporter in Nitrosomonas europaea".
- ↑ Li, Xin; Jayachandran, Sanjay; Nguyen, Hiep-Hoa T.; Chan, Michael K. (2007-12-04). "Structure of the Nitrosomonas europaea Rh protein". Proceedings of the National Academy of Sciences. 104 (49): 19279–19284. Bibcode:2007PNAS..10419279L. doi:10.1073/pnas.0709710104. ISSN 0027-8424. PMC 2148281. PMID 18040042.
- 1 2 3 Kowalchuk, George A.; Stephen, John R. (October 2001). "Ammonia-Oxidizing Bacteria: A Model for Molecular Microbial Ecology". Annual Review of Microbiology. 55 (1): 485–529. doi:10.1146/annurev.micro.55.1.485. ISSN 0066-4227. PMID 11544365.
- 1 2 3 Arp, Daniel J.; Stein, Lisa Y. (January 2003). "Metabolism of Inorganic N Compounds by Ammonia-Oxidizing Bacteria". Critical Reviews in Biochemistry and Molecular Biology. 38 (6): 471–495. doi:10.1080/10409230390267446. ISSN 1040-9238. PMID 14695127. S2CID 28714419.
- 1 2 Madigan, Michael T. (2007). Biologia dei microrganismi. p. 143. ISBN 978-88-408-1405-6.
- 1 2 3 4 González-Cabaleiro, Rebeca; Curtis, Thomas Peter; Ofiţeru, Irina Dana (May 2019). "Bioenergetics analysis of ammonia-oxidizing bacteria and the estimation of their maximum growth yield". Water Research. 154: 238–245. doi:10.1016/j.watres.2019.01.054. PMID 30798178.
- ↑ "Nitrosomonas europaea ATCC 19718 - Home". Archived from the original on 2009-07-03. Retrieved 2008-10-25.
- ↑ "Nitrosomonas maps - Encyclopedia of Life". eol.org. Retrieved 2020-11-26.
- ↑ Marine Microbiology Ecology and Applications. 2011.
- ↑ Marsh, K. L., G. K. Sims, and R. L. Mulvaney. 2005. Availability of urea to autotrophic ammonia-oxidizing bacteria as related to the fate of 14C- and 15N-labeled urea added to soil. Biol. Fert. Soil. 42:137-145.
- 1 2 "Nitrosomonas - microbewiki". microbewiki.kenyon.edu. Retrieved 2020-11-26.
- ↑ Rodgers, G. A. (1986-10-01). "Nitrification inhibitors in agriculture". Journal of Environmental Science and Health, Part A. 21 (7): 701–722. doi:10.1080/10934528609375320. ISSN 0360-1226.
- 1 2 Cho, Kyungjin; Shin, Seung Gu; Lee, Joonyeob; Koo, Taewoan; Kim, Woong; Hwang, Seokhwan (2016-08-01). "Nitrification resilience and community dynamics of ammonia-oxidizing bacteria with respect to ammonia loading shock in a nitrification reactor treating steel wastewater". Journal of Bioscience and Bioengineering. 122 (2): 196–202. doi:10.1016/j.jbiosc.2016.01.009. ISSN 1389-1723. PMID 26896313.
- ↑ Notay, Manisha; Saric‐Bosanac, Suzana; Vaughn, Alexandra R.; Dhaliwal, Simran; Trivedi, Megha; Reiter, Paloma N.; Rybak, Iryna; Li, Connie C.; Weiss, Larry B.; Ambrogio, Lauren; Burney, Waqas (2020). "The use of topical Nitrosomonas eutropha for cosmetic improvement of facial wrinkles". Journal of Cosmetic Dermatology. 19 (3): 689–693. doi:10.1111/jocd.13060. hdl:2027.42/154401. ISSN 1473-2165. PMID 31257694. S2CID 195759883.
- ↑ Kramer, Shelli (2016-03-30). "Nitrosomonas eutropha: A Study of the Effects of Nitrosomonas on Pathogenic Bacterium and the Effects of Current Hygiene Habits on the Colonization of Nitrosomonas Within Our Normal Flora". JCCC Honors Journal. 7 (1). ISSN 2154-7548.
- George M. Garrity: Bergey's manual of systematic bacteriology. 2. Auflage. Springer, New York, 2005, Vol. 2: The Proteobacteria Part C: The Alpha-, Beta-, Delta-, and Epsilonproteobacteria ISBN 0-387-24145-0
- Winogradsky, S. 1892. Contributions à la morphologie des organismes de la nitrification. Archives des Sciences Biologiques (St. Petersbourg). 1:86-137.